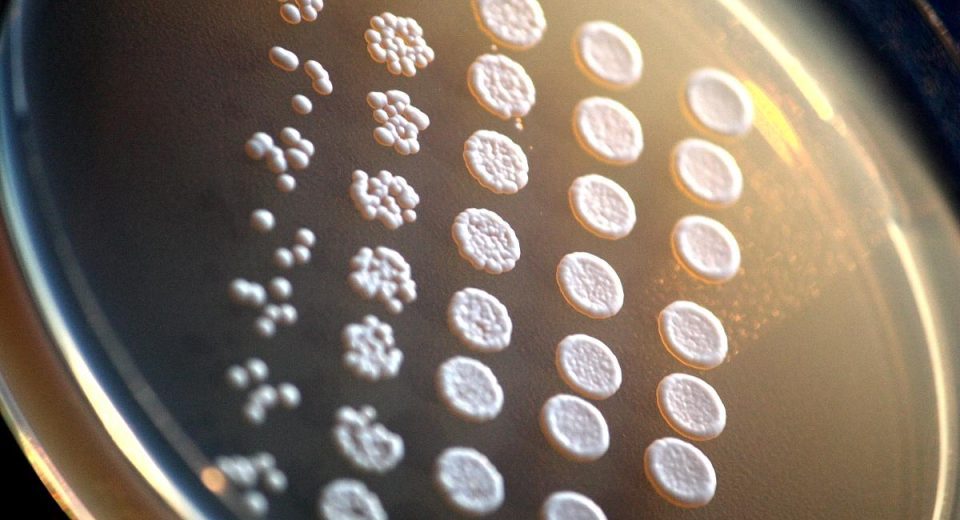

UEFA Champions League 2024-25: Benfica sees off Monaco in thriller to reach last 16
UEFA Champions League 2024-25: Benfica sees off Monaco in thriller to reach last 16 Benfica held determined AS Monaco to a 3-3 draw in a thrilling second leg of their Champions League knockout phase playoff on Tuesday for a 4-3 aggregate win that earned the hosts a place in the competition’s last 16. Benfica, which […]